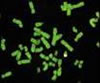

| Kromozom |

Kromozom |

Kromozom |

Kromozom |
Kromozom |
| Kalıtsal madde.Hücre çekirdeği içindeki kalıtsal maddedir. Genleri içeren iplik ya da çubuk biçimindeki yapılardır. Prokaryot ve ökaryot hücrelerde üzerlerinde genleri taşıyan DNA ve nükleoproteinden oluşmuş yapıdır. 1-Hücre çekirdeği içindeki kalıtsal maddedir. Genleri içeren iplik ya da çubuk biçimindeki yapılardır. 2-Prokaryot ve ökaryot hücrelerde üzerlerinde genleri taşıyan DNA ve nükleoproteinden oluşmuş yapı. 3.Ökaryot hücreli canlılarda, hücrelerdeki kromozom sayıları açısından iki çeşit hücre görülebilir. Bu hücre tiplerinden birisi n (haploid) kromozomlu olan sperm ve yumurta gibi üreme hücreleri iken, diğeri 2n (diploid) kromozomlu vücut hücreleridir. Örneğin insanda 46 kromozom bulunur. |